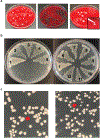

Adaptive evolution of virulence and persistence in carbapenem-resistant Klebsiella pneumoniae
- PMID: 32284589
- PMCID: PMC9194776
- DOI: 10.1038/s41591-020-0825-4
Adaptive evolution of virulence and persistence in carbapenem-resistant Klebsiella pneumoniae
Erratum in
-
Author Correction: Adaptive evolution of virulence and persistence in carbapenem-resistant Klebsiella pneumoniae.Nat Med. 2020 Aug;26(8):1307. doi: 10.1038/s41591-020-0974-5. Nat Med. 2020. PMID: 32587394 Free PMC article.
Abstract
Among the most urgent public health threats is the worldwide emergence of carbapenem-resistant Enterobacteriaceae1-4, which are resistant to the antibiotic class of 'last resort'. In the United States and Europe, carbapenem-resistant strains of the Klebsiella pneumoniae ST258 (ref. 5) sequence type are dominant, endemic6-8 and associated with high mortality6,9,10. We report the global evolution of pathogenicity in carbapenem-resistant K. pneumoniae, resulting in the repeated convergence of virulence and carbapenem resistance in the United States and Europe, dating back to as early as 2009. We demonstrate that K. pneumoniae can enhance its pathogenicity by adopting two opposing infection programs through easily acquired gain- and loss-of-function mutations. Single-nucleotide polymorphisms in the capsule biosynthesis gene wzc lead to hypercapsule production, which confers phagocytosis resistance, enhanced dissemination and increased mortality in animal models. In contrast, mutations disrupting capsule biosynthesis genes impair capsule production, which enhances epithelial cell invasion, in vitro biofilm formation and persistence in urinary tract infections. These two types of capsule mutants have emerged repeatedly and independently in Europe and the United States, with hypercapsule mutants associated with bloodstream infections and capsule-deficient mutants associated with urinary tract infections. In the latter case, drug-tolerant K. pneumoniae can persist to yield potentially untreatable, persistent infection.
Figures

References
-
- Antibiotic Resistance Threats in the United States (Centers for Disease Control and Prevention, 2013).
-
- Rapid Risk Assessment: Carbapenem-resistant Enterobacteriaceae—First update (European Centre for Disease Prevention and Control, 2018).
-
- Antimicrobial Resistance—Global Report on Surveillance (World Health Organization, 2014).
Publication types
MeSH terms
Substances
Grants and funding
LinkOut - more resources
Full Text Sources
Other Literature Sources
Molecular Biology Databases